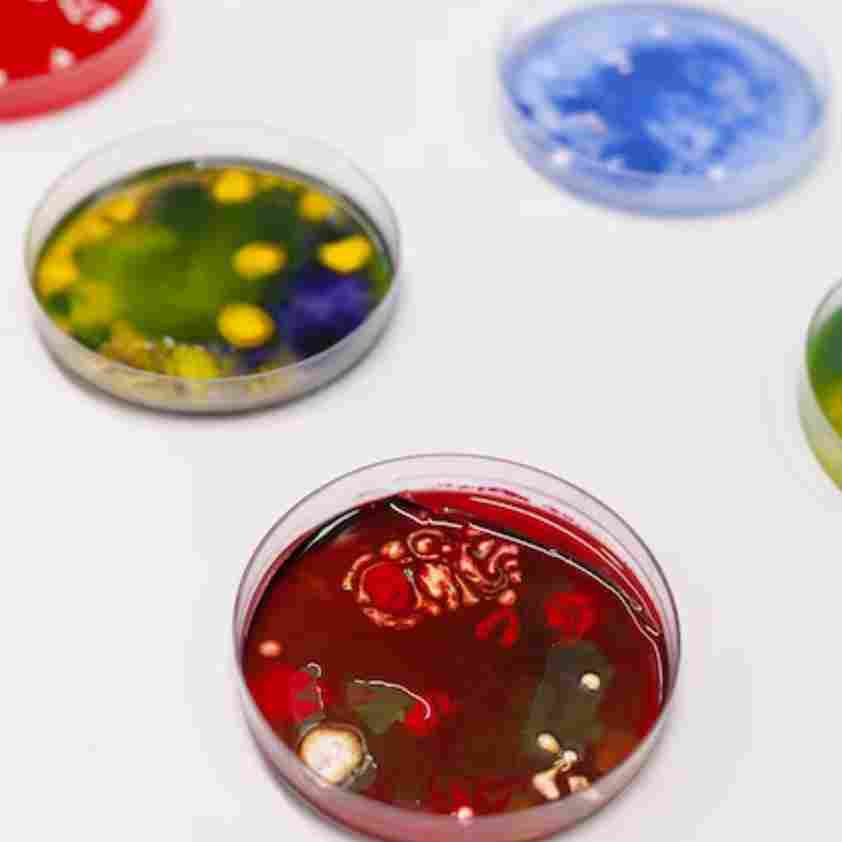

Severity: Warning
Message: fopen(/tmp/ci_session4479d87e70b786c4b1dfb35de6075b765706f2a7): Failed to open stream: No space left on device
Filename: drivers/Session_files_driver.php
Line Number: 176
Backtrace:
File: /home/startup/public_html/index.php
Line: 318
Function: require_once
Severity: Warning
Message: session_start(): Failed to read session data: user (path: /tmp)
Filename: Session/Session.php
Line Number: 143
Backtrace:
File: /home/startup/public_html/index.php
Line: 318
Function: require_once
Guaranteed safe checkout
We offer you a full refund within 30 days of purchase.
Automatically receive free standard shipping on every order.

This company Established in 1984, Mr. Rahul Karan started his first Manufacturing and Exporting unit in Baroda, Gujarat to produce Vat Dye, Solubilised Dyes and much more. for catering the needs of the domestic textile industries. Our offered products are processed in compliance with the pre-defined industry norms and tested to ensure their premium quality. Our raw material is sourced by our skilled procuring agents from reliable and certified vendors of the market in compliance with international quality standards.
Prop.
Mr. Karan Jain
Annual Turnover
Rs. 10 - 25 Crore
Year of Establishment
1984
Primary Business
Manufacturer, Exporter
Category : Milk
